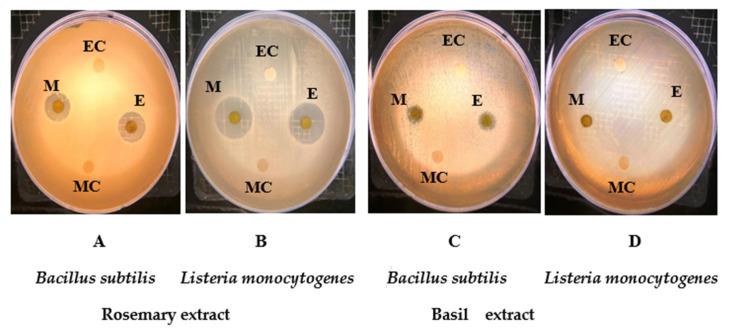

基于煮沸技术的食品加工对罗勒和迷迭香生物活性和抗菌性能的影响。
Boiling Technique-Based Food Processing Effects on the Bioactive and Antimicrobial Properties of Basil and Rosemary.
机构信息
Department of Food Science & Nutrition, College of Food and Agricultural Sciences, King Saud University, Riyadh 11451, Saudi Arabia.
出版信息
Molecules. 2021 Dec 4;26(23):7373. doi: 10.3390/molecules26237373.
Rosemary () and basil ( Linn) are mostly used as herbal teas, made by steeping whole or ground herbs in boiling water. Hence, it is important to know the effect of boiling time on the bioactivity of these herbs. The effect of different boiling times (5, 10, and 15 min) on the antioxidant and antimicrobial properties, and some selected phenolic compounds of these herbs was examined in this study. Experimental results revealed that basil displayed the highest total polyphenol content (TPC), total flavonoid content (TFC), and antioxidant activity when it was boiled for 5 min, and the lowest TPC was obtained when it was boiled for 15 min. On the other hand, rosemary had the highest TPC, TFC, and antioxidant potential after being boiled for 15 min, while it had the lowest after being boiled for 5 min. There was no growth inhibition of rosemary extracts against gram-negative bacteria, whereas higher growth inhibition was observed against gram-positive bacteria. The MIC and MBC of rosemary ethanolic extract against were 5 and 5 mg/mL and against were 10 and 10 mg/mL, respectively. While MIC and MBC of methanolic extract against were 5 and 5 mg/mL and against were and 5 and 5 mg/mL, respectively. Salicylic acid was the most abundant (324.7 mg/100 g dry weight (dw)) phenolic compound in the rosemary sample boiled for 5 min, and acetyl salicylic acid was the most abundant (122.61 mg/10 g dw) phenolic compound in the basil sample boiled for 15 min.
迷迭香(Rosemary)和罗勒(Basil)大多被用作草药茶,通过将整株或磨碎的草药浸泡在沸水中来制作。因此,了解煮沸时间对这些草药生物活性的影响非常重要。本研究考察了不同煮沸时间(5、10 和 15 分钟)对这些草药的抗氧化和抗菌特性以及一些选定的酚类化合物的影响。实验结果表明,罗勒在煮沸 5 分钟时表现出最高的总多酚含量(TPC)、总黄酮含量(TFC)和抗氧化活性,而在煮沸 15 分钟时 TPC 最低。另一方面,迷迭香在煮沸 15 分钟时具有最高的 TPC、TFC 和抗氧化潜力,而在煮沸 5 分钟时则最低。迷迭香提取物对革兰氏阴性菌没有生长抑制作用,而对革兰氏阳性菌则有更高的抑制作用。迷迭香乙醇提取物对 的 MIC 和 MBC 分别为 5 和 5mg/mL,对 的 MIC 和 MBC 分别为 10 和 10mg/mL。而甲醇提取物对 的 MIC 和 MBC 分别为 5 和 5mg/mL,对 的 MIC 和 MBC 分别为 5 和 5mg/mL。在煮沸 5 分钟的迷迭香样品中,水杨酸是最丰富的酚类化合物(324.7mg/100g 干重(dw)),在煮沸 15 分钟的罗勒样品中,乙酰水杨酸是最丰富的酚类化合物(122.61mg/10g dw)。